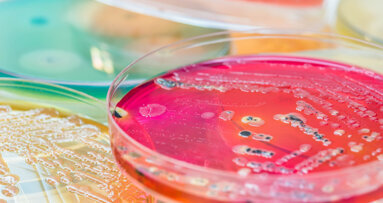
“Like bacteria hitch-hiking on the fungi”—study shows how organisms “walk” across teeth

COLOGNE, Germany: At IDS 2019, Austria-based company W&H decided not to host one large press conference, but rather to invite the press to attend specially stylised “walk and talk” tours. Held at different times throughout the trade show at the W&H booth, the tours allowed participants to get up close and personal with the latest products released at the fair. On Wednesday, Dental Tribune International attended an afternoon tour.
Leading the tour was Simon Niedermüller, Director of Business Management. Besides a number of products that the company had on display, W&H launched its latest cloud-based technology, the ioDent system. “The ioDent platform is an Internet of things platform connecting different W&H products, from our implantology products through to our sterilisers, but also provides service support to the clinics,” explained Niedermüller. With many features, the new platform’s intuitive interface enables the user to predefine all the treatment details, implant positions and necessary program steps, which are customised for each patient and can be planned and configured prior to the treatment.
Other products showcased during the tour and launched at IDS for the first time were the new Lisa and Lara steriliser systems, and a new prophylactic portfolio. For more information on W&H, visit their booth at Hall 10.1, Booth C018.
Tags:
COLOGNE, Germany: Oral diseases affect 3.5 billion people worldwide, and untreated dental caries is among the most prevalent non-communicable diseases. In ...
COLOGNE, Germany: The International Dental Show (IDS) is a brilliant place for companies to showcase their advancements in technology and new products. At ...
LONDON, UK: Kissing. Who doesn’t like a good old wet one on the lips? On 22 June, with different levels of intensity, the UK is puckering up on National ...
LONDON, UK: Despite dental settings presenting a significantly elevated risk of infection for those in and beside the chair, testing patients for the ...
COLOGNE, Germany: At the W&H press event on Monday, a visibly good-humoured Managing Director Peter Malata ushered in the upcoming International Dental Show...
PHILADELPHIA, US: A research team from the University of Pennsylvania has found that, within hours of growth, groupings of bacteria were able to “leap” ...
AMSTERDAM, Netherlands: In front of an appreciative audience, the Sunstar Foundation welcomed a variety of notable guests both from and outside of ...
COLOGNE, Germany: Sterify Gel is a mucoadhesive polymer hydrogel in a pre-filled syringe for the treatment of periodontal disease. It is intended to promote...
COLOGNE, Germany: Dentistry has evolved through many different eras. Today, it is about choice and creating an individual treatment option for each patient,...
BERLIN, Germany: The non-profit CleanImplant Foundation recently participated in the 2023 International Dental Show (IDS). For its fifth iteration, this ...
Live webinar
Mon. 22 June 2026
8:00 pm EST (New York)
Live webinar
Tue. 23 June 2026
1:00 pm EST (New York)
Live webinar
Tue. 23 June 2026
3:00 pm EST (New York)
Live webinar
Wed. 24 June 2026
8:00 am EST (New York)
Live webinar
Wed. 24 June 2026
11:00 am EST (New York)
Live webinar
Wed. 24 June 2026
12:30 pm EST (New York)
Dr. med. dent. Britta Hahn
Live webinar
Thu. 25 June 2026
2:00 pm EST (New York)
Dr. Hatem Algraffee, Cat Edney



 Austria / Österreich
Austria / Österreich
 Bosnia and Herzegovina / Босна и Херцеговина
Bosnia and Herzegovina / Босна и Херцеговина
 Bulgaria / България
Bulgaria / България
 Croatia / Hrvatska
Croatia / Hrvatska
 Czech Republic & Slovakia / Česká republika & Slovensko
Czech Republic & Slovakia / Česká republika & Slovensko
 France / France
France / France
 Germany / Deutschland
Germany / Deutschland
 Greece / ΕΛΛΑΔΑ
Greece / ΕΛΛΑΔΑ
 Hungary / Hungary
Hungary / Hungary
 Italy / Italia
Italy / Italia
 Netherlands / Nederland
Netherlands / Nederland
 Nordic / Nordic
Nordic / Nordic
 Poland / Polska
Poland / Polska
 Portugal / Portugal
Portugal / Portugal
 Romania & Moldova / România & Moldova
Romania & Moldova / România & Moldova
 Slovenia / Slovenija
Slovenia / Slovenija
 Serbia & Montenegro / Србија и Црна Гора
Serbia & Montenegro / Србија и Црна Гора
 Spain / España
Spain / España
 Switzerland / Schweiz
Switzerland / Schweiz
 Turkey / Türkiye
Turkey / Türkiye
 UK & Ireland / UK & Ireland
UK & Ireland / UK & Ireland
 Brazil / Brasil
Brazil / Brasil
 Canada / Canada
Canada / Canada
 Latin America / Latinoamérica
Latin America / Latinoamérica
 USA / USA
USA / USA
 China / 中国
China / 中国
 India / भारत गणराज्य
India / भारत गणराज्य
 Pakistan / Pākistān
Pakistan / Pākistān
 Vietnam / Việt Nam
Vietnam / Việt Nam
 ASEAN / ASEAN
ASEAN / ASEAN
 Israel / מְדִינַת יִשְׂרָאֵל
Israel / מְדִינַת יִשְׂרָאֵל
 Algeria, Morocco & Tunisia / الجزائر والمغرب وتونس
Algeria, Morocco & Tunisia / الجزائر والمغرب وتونس
 Middle East / Middle East
Middle East / Middle East

To post a reply please login or register